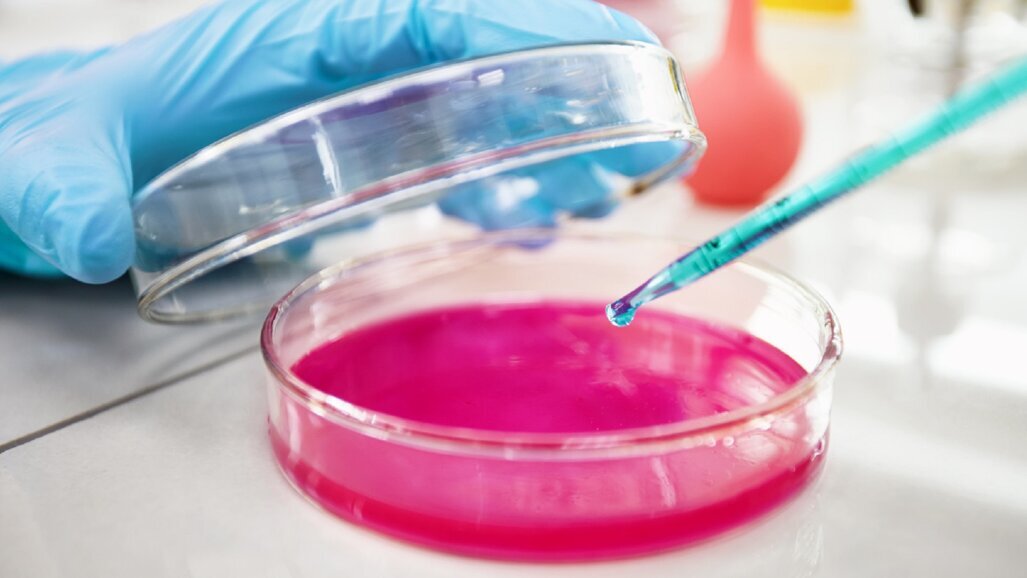
Diptool – polskie narzędzie do szybkiej identyfikacji nowych leków antybakteryjnych

W czasach, gdy odporność bakterii na antybiotyki stanowi globalne wyzwanie zdrowotne, naukowcy poszukują nowych sposobów zwalczania mikroorganizmów. Dr Mateusz Rzycki z Politechniki Wrocławskiej opracował narzędzie, które ma przyspieszyć prace nad nowymi związkami antybakteryjnymi opracował.
Diptool to oprogramowanie przesiewowe do szybkiego określania powinowactwa środka przeciwdrobnoustrojowego na podstawie energii swobodnej do różnych typów błon lipidowych, a więc także błon komórkowych bakterii. Narzędzie pozwala na modelowanie interakcji międzycząsteczkowych, co umożliwia wizualizację trajektorii cząstek i analizę ich energii swobodnej. Jest zdecydowanie szybsze niż klasyczne metody i ma przyjazny użytkownikowi graficzny interfejs. Pracując na nim, badacz może uruchamiać symulacje z zadanymi przez siebie parametrami i na bieżąco śledzić wyniki oraz różne statystyki w postaci graficznej.
Badania nad zupełnie nowymi związkami antybakteryjnymi są bardzo czasochłonne – tym bardziej, że do przetestowania są miliony cząstek. Nowe narzędzie może skutecznie przyspieszyć te prace. Jak tłumaczy dr Rzycki, dzięki Diptool naukowiec może prowadzić wirtualne eksperymenty na komputerze, jeszcze zanim dany związek chemiczny zostanie zsyntetyzowany w laboratorium. Otwiera to zupełnie nowe możliwości, jeśli chodzi o poszukiwania nowych klas detergentów i środków przeciwdrobnoustrojowych. „Nasz model jest naprawdę prosty. Umożliwia szybkie wyłowienie pewnych cząstek z wielkich baz danych. W obecnych czasach takie bazy są absurdalnie ogromne, dlatego dobrze jest mieć takiego pomocnika, który nie angażując za bardzo naszych zasobów czasowych i komputerowych, jest w stanie wyodrębnić te najbardziej obiecujące związki” – podkreśla autor narzędzia.
Artykuły opisujące prace nad narzędziem Diptool oraz jego skutecznością dr Rzycki wraz ze współpracownikami: prof. Sebastianem Kraszewskim i prof. Martą Gładysiewicz-Kudrawiec z Politechniki Wrocławskiej opisał na łamach „Scientific Reports” i „Materials”.
„Diptool pozwala ocenić wybrane związki przeciwdrobnoustrojowych na podstawie ich własności. Dzięki niemu mogliśmy zaproponować udoskonaloną klasyfikację tych związków pod kątem ich interakcji z błonami komórkowymi i potencjalnej aktywności przeciwdrobnoustrojowej. Podejście to ma szczególną wartość w analizie cząstek i opracowywaniu nowych leków ukierunkowanych na szczepy bakteryjne oporne na antybiotyki” – tłumaczy dr Rzycki.
Tworzenie narzędzia rozpoczął w ramach przygotowywania swojego doktoratu. Zaczął się wtedy zastanawiać się, czy istnieją wspólne cechy np. strukturalne, które wykazują wszystkie związki antybakteryjne. „Wraz z promotorem szukaliśmy parametrów, które pozwolą ocenić, że związek A jest skuteczniejszy wobec jakiejś bakterii niż związek B” – wyjaśnia rozmówca. Metod takich poszukiwań jest wiele, jednak naukowcy nie byli z nich zadowoleni, przede wszystkim dlatego, że nie dało się ich między sobą w pełni porównywać, ponieważ wykorzystywały różne protokoły eksperymentalne. „Dlatego my, jako teoretycy, postanowiliśmy podjeść do tego tematu inaczej, sprowadzając wszystko do wartości liczbowych. Wykorzystaliśmy metodę, która nazywa się QSAR” – mówi.
QSAR (quantitative structure-activity relationship) to technika, która w różny sposób stara się powiązać aktywność biologiczną z rozmaitymi parametrami strukturalnymi danej grupy związków. W toku badań okazało się, że kilka spośród tych parametrów powtarza się i można je uznać za znaczące. Były to m.in. moment dipolowy związków, współczynnik podziału oraz rozmiar cząsteczki (stosunek długości do szerokości).
Następnie dr Rzycki zaimplementował te cechy w postaci numerycznej, korzystając ze znanych metod całkowania równań ruchu i zależności układów termodynamicznych. „Są pewne rozwiązania numeryczne, które pozwalają na zastosowanie tych praw do takich zamkniętych układów, z jakimi mieliśmy do czynienia. W naszym wypadku ograniczaliśmy wszystko do oddziaływania dipoli ze sobą, czyli ze wszystkich wcześniej wyodrębnionych parametrów skupiliśmy się wyłącznie na obserwacjach ruchu i energii układu” – opowiada.
Naukowcy przygotowali model uproszczonej błony lipidowej, jednak podeszli do tego trochę inaczej niż się to zwykle robi. „Nasza cząstka była reprezentowana tylko przez jeden dipol o odpowiedniej wartości, a sama błona przez specyficzny układ dipoli, określony na podstawie dotychczasowych badań z zakresu dynamiki molekularnej” – wyjaśnia specjalista. „Następnie badaliśmy, jak zachowuje się energia takiego układu, czyli jak jedne cząstki oddziałują na drugie” – dodaje.
Obserwując, jak dana cząstka wchodzi w interakcję z błoną i wyliczając energię, jaka się z tym wiąże, można było ocenić, czy dany związek jest dobrym kandydatem do dalszych testów eksperymentalnych, czy też nie. Jednym słowem: czy może być potencjalnym środkiem antybakteryjnym.
Dr Rzycki podkreśla, że dzięki Diptool cała ta procedura odbywa się o wiele szybciej niż pozwalały na to klasyczne metody. „Nasze narzędzie umożliwia formułowanie podobnych wniosków, ale zajmuje zdecydowanie mniej czasu. Przestudiowanie jednej cząsteczki zajmuje nam minuty lub godziny, a w przypadku tradycyjnych metod dynamiki molekularnej są to dni lub tygodnie” – podkreśla. „Diptool bardzo przyspiesza identyfikację obiecujących związków, które następnie mogą być testowane eksperymentalnie przez badaczy” – tłumaczy.
Skuteczność narzędzia jest wysoka. Jak mówi dr Rzycki, aktywność cząsteczek, scharakteryzowana w Diptool była zbieżna względem wyników z dotychczas stosowanych, klasycznych narzędzi. „Nasze badania pokazują, że ta metoda jest obiecująca i wykazuje wysoką skuteczność” – podsumowuje naukowiec.
źródło: MNiSW
Pod koniec lutego br. (24.02.2018 r.) w Warszawie miało miejsce wydarzenie, które przyciągnęło uwagę wielu dentystów z całej Polski. Promujący ...
Statystyczny Polak przyjmuje leki przeciwbólowe 7 razy w miesiącu, tymczasem nadużywanie leków i suplementów może opóźnić ...
Prostowanie zębów bez aparatu, rozjaśnianie uśmiechu bez wybielania, błyskawiczny bonding zamiast licówek – to szybkie, skuteczne i ...
W Polskiej Federacji Szpitali zrzeszonych jest już 37 placówek – to lecznice o zróżnicowanej strukturze organizacyjnej funkcjonujące ...
Naukowcy i eksperci z ośrodków badawczych w Europie oraz 5 innowacyjnych firm farmaceutycznych stworzą platformę wymiany informacji i ...
Naukowcy i eksperci z ośrodków badawczych w Europie oraz 5 innowacyjnych firm farmaceutycznych stworzą platformę wymiany informacji i ...
W związku z wystąpieniem zagrożenia zakażeniem żółtaczką, lubelski sanepid chce przebadać pod kątem zarażenia wirusowym zapaleniem wątroby...
Choć czasami wyśmiewane jako oznaka próżności, fotografie z autoportretami (selfie) nie są pozbawione swoich zalet. Jedną z takich korzyści, zdaniem...
Badanie, które może pomóc we wczesnej identyfikacji raka płaskonabłonkowego jamy ustnej (OSCC) przeprowadzone zostało przez brazylijskich naukowców, ...
Do 13 czerwca zakończy się audyt na 12 uczelniach, które kształcą na nowoutworzonych kierunkach lekarskich lub planują ich uruchomienie mimo ...
Webinarium na żywo
śro. 8 lipca 2026
2:00 (CET) Warsaw
Dr. Mark Donaldson BSP, ACPR, PHARMD, FASHP, FACHE
Webinarium na żywo
śro. 8 lipca 2026
2:00 (CET) Warsaw
Webinarium na żywo
śro. 8 lipca 2026
7:00 (CET) Warsaw
Prof. Gianluca Gambarini MD, DDS
Webinarium na żywo
czw. 9 lipca 2026
4:00 (CET) Warsaw
Dr. Jae Seon Kim DDS, MSD, FACP, CDT
Webinarium na żywo
czw. 9 lipca 2026
7:00 (CET) Warsaw
Dr. Armando Lopes, Dr. Carlos Moura Guedes
Webinarium na żywo
pią. 10 lipca 2026
2:00 (CET) Warsaw
Webinarium na żywo
pon. 13 lipca 2026
5:30 (CET) Warsaw



 Austria / Österreich
Austria / Österreich
 Bośnia i Hercegowina / Босна и Херцеговина
Bośnia i Hercegowina / Босна и Херцеговина
 Bułgaria / България
Bułgaria / България
 Chorwacja / Hrvatska
Chorwacja / Hrvatska
 Czechy i Słowacja / Česká republika & Slovensko
Czechy i Słowacja / Česká republika & Slovensko
 Francja / France
Francja / France
 Niemcy / Deutschland
Niemcy / Deutschland
 Grecja / ΕΛΛΑΔΑ
Grecja / ΕΛΛΑΔΑ
 Węgry / Hungary
Węgry / Hungary
 Włochy / Italia
Włochy / Italia
 Holandia / Nederland
Holandia / Nederland
 nordycki / Nordic
nordycki / Nordic
 Polska / Polska
Polska / Polska
 Portugalia / Portugal
Portugalia / Portugal
 Rumunia i Mołdawia / România & Moldova
Rumunia i Mołdawia / România & Moldova
 Słowenia / Slovenija
Słowenia / Slovenija
 Serbia i Czarnogóra / Србија и Црна Гора
Serbia i Czarnogóra / Србија и Црна Гора
 Hiszpania / España
Hiszpania / España
 Szwajcaria / Schweiz
Szwajcaria / Schweiz
 indyk / Türkiye
indyk / Türkiye
 Wielka Brytania i Irlandia / UK & Ireland
Wielka Brytania i Irlandia / UK & Ireland
 Międzynarodowy / International
Międzynarodowy / International
 Brazylia / Brasil
Brazylia / Brasil
 Kanada / Canada
Kanada / Canada
 Ameryka Łacińska / Latinoamérica
Ameryka Łacińska / Latinoamérica
 USA / USA
USA / USA
 Chiny / 中国
Chiny / 中国
 Indie / भारत गणराज्य
Indie / भारत गणराज्य
 Pakistan / Pākistān
Pakistan / Pākistān
 Wietnam / Việt Nam
Wietnam / Việt Nam
 ASEAN / ASEAN
ASEAN / ASEAN
 Izrael / מְדִינַת יִשְׂרָאֵל
Izrael / מְדִינַת יִשְׂרָאֵל
 Algieria, Maroko i Tunezja / الجزائر والمغرب وتونس
Algieria, Maroko i Tunezja / الجزائر والمغرب وتونس
 Bliski Wschód / Middle East
Bliski Wschód / Middle East

To post a reply please login or register